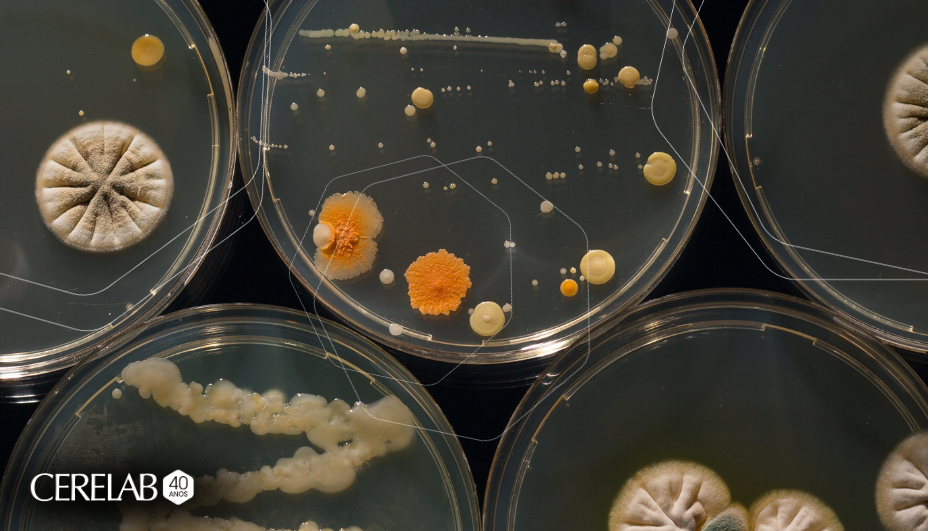

O que são microrganismos deteriorantes e por que eles impactam sua indústria?
Muitas vezes, o foco da segurança dos alimentos está voltado exclusivamente para os patógenos (como Coliformes, Salmonela ou Listeria), que representam riscos diretos à saúde pública. No entanto, para a gestão de qualidade e eficiência operacional, os microrganismos deteriorantes são protagonistas de um desafio silencioso, mas extremamente oneroso.
O que são deteriorantes?
Diferente dos patógenos, os deteriorantes geralmente não causam doenças. Sua ação é metabólica: eles utilizam os componentes do alimento (açúcares, proteínas, gorduras) para crescer, alterando as propriedades sensoriais do produto.
Os principais sinais de deterioração:
Alterações de Cor: Manchas superficiais ou descoloração.
Modificações de Textura: Viscosidade, amolecimento de tecidos vegetais ou separação de fases.
Odor e Sabor: Produção de gases, azedamento (fermentação) ou rancidez.
Estufamento de embalagens: Resultado da produção de $CO_2$ por leveduras ou bactérias esporuladas.
Por que monitorá-los é estratégico?
O controle de deteriorantes não é apenas uma questão de conformidade, mas de saúde financeira da planta:
Redução de Food Waste: Identificar a carga microbiana inicial permite prever o comportamento do produto.
Extensão de Shelf-life: Menores contagens de deteriorantes garantem que o produto chegue ao fim da validade com a mesma experiência sensorial do dia da fabricação.
Proteção da Marca: O consumidor que abre um produto com odor alterado, mesmo que seguro para consumo, perde a confiança na marca.
Otimização de Processos: Picos de deteriorantes podem indicar falhas na higienização (CIP), problemas na cadeia de frio ou baixa qualidade de matérias-primas.
Como a Cerelab apoia sua indústria?
Contamos com metodologias precisas para a contagem de bolores e leveduras, bactérias láticas, psitrotróficos e outros grupos específicos que afetam o seu segmento. Entender a microbiota do seu processo é o primeiro passo para garantir a estabilidade do seu produto no mercado.
Sua indústria monitora os indicadores de deterioração como parte da estratégia de shelf-life?
Siga-nos no LinkedIn e fique por dentro das novidades do setor!